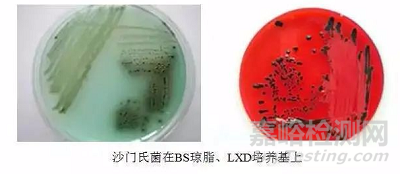

沙門氏菌屬(Salmonella)是一群寄生在人類和動物腸道中��,生化反應和抗原結構相關的革蘭氏陰性桿菌。沙門氏菌屬細菌的血清型現(xiàn)已達2500多種��。根據(jù)DNA同源性,分兩個種��,即腸道沙門氏菌(S.enterica)和邦戈沙門氏菌(S.bongori)��。腸道沙門氏菌又分6個亞種,能感染人類的沙門氏菌血清型��,約1400多種��,主要在第一亞種中��,即腸道沙門氏菌腸道亞種(S. enterica subsp. Enterica)��。
沙門氏菌屬中少數(shù)血清型如傷寒沙門氏菌、甲型副傷寒沙門氏菌��、乙型副傷寒沙門氏菌和丙型副傷寒沙門氏菌是人的病原菌��,對人類有直接的致病作用,引起腸熱癥��,對非人類宿主不致病��。絕大多數(shù)血清型宿主范圍廣泛,家畜��、家禽��、野生脊椎動物以及冷血動物��、軟體動物、環(huán)形動物��、節(jié)肢動物(包括蒼蠅)等均可帶菌��,其中部分沙門氏菌是人獸共患病的病原菌,可引起人類食物中毒或敗血癥��。
所以將沙門氏菌檢驗規(guī)定為食品致病性菌種檢驗中的重要項目��,它的檢測過程一般包括樣品前增菌、選擇性增菌��、選擇性平板分離劃線��、初步生化鑒定(確定可疑菌)、生化鑒定��、血清學鑒定共計6個步驟��。
下面我們就開始對整個檢測過程進行分析梳理:(GB4789.4-2016)
1. 樣品處理及預增菌
無菌操作稱取25g(mL)樣品,置于盛有225mL緩沖蛋白胨水(BPW)的無菌均質杯��、均質袋或合適容器內,根據(jù)標準要求進行均質��。若樣品為液體��,即可以均質��,也可以震蕩混勻。于36℃±1℃培養(yǎng)8h-18h��。
前增菌的緩沖蛋白胨水(BPW),為非選擇性的增菌培養(yǎng)基��,培養(yǎng)過程中緩沖體系能將培養(yǎng)基維持在較高pH��,有利于受損細胞的恢復��。
蛋白胨提供碳源和氮源滿足細菌生長的需求;氯化鈉可維持均衡的滲透壓;磷酸二氫鉀和磷酸氫二鈉是緩沖劑。
2. 選擇性增菌
將培養(yǎng)后BPW搖勻��,取1mL轉種于10mL 四硫磺酸鈉煌綠增菌液(TTB)��,于42℃±1℃培養(yǎng)18h-24h��,同時再取1mL轉種于亞硒酸鹽胱氨酸增菌液(SC)��,于36℃±1℃培養(yǎng)18h-24h��。
TTB增菌液的配制有兩個注意事項��,一是碳酸鈣是TTB的正常成分��,作用是中和吸收有毒性的代謝物質(主要是培養(yǎng)基酸堿度的變化對菌生長的影響)��。但是碳酸鈣不溶于水��,所以TTB有沉淀是正常的��,分裝時一定搖勻分裝��。二是四硫磺酸鈉是TTB抑制性的核心成分,培養(yǎng)基也以此命名��,但成分表中并沒有四硫磺酸鈉,它是在碘液煌綠加入后��,硫代硫酸鈉經(jīng)碘氧化生成的��。四硫磺酸鈉對大腸菌群有抑制作用��,但不穩(wěn)定��,所以碘液和煌綠必須在臨用前加入��。
SC培養(yǎng)后��,若菌生長��,培養(yǎng)液會變紅��,但是變紅不意味著沙門氏菌的存在��,還需要往下進行��。
3. 選擇性分離
將培養(yǎng)后的TTB和SC搖勻,用接種環(huán)分別劃線接種于BS瓊脂平板和XLD瓊脂平板��,或HE瓊脂平板��,或沙門顯色平板��,于36℃±1℃分別培養(yǎng)40h-48h或18h-24h��,之后觀察各個平板上菌落特征��。
單菌落的菌落特征最為典型��,利于觀察,為獲得大量單菌落��,一般建議采用三區(qū)或四區(qū)劃線��,這樣分離效果好,更容易出現(xiàn)單菌落��。
BS瓊脂是沙門氏菌檢驗中的必用平板��,它的優(yōu)勢在于對傷寒沙門氏菌的檢出率比傳統(tǒng)平板高30-80%不等��。同時在沙門顯色培養(yǎng)基出現(xiàn)之前��,對變形菌的抑制性和特異性均好于同類培養(yǎng)基��。所以BS瓊脂一直是沙門氏菌選擇分離的首選培養(yǎng)基��。
BS瓊脂上沙門氏菌菌落特征:菌落為黑色有金屬光澤��、棕褐色或灰色,菌落周圍培養(yǎng)基可呈黑色或棕色��;有些菌株形成灰綠色的菌落��,周圍培養(yǎng)基不變。
XLD瓊脂上沙門氏菌菌落特征:菌落呈粉紅色,帶或不帶黑色中心��,有些菌株可呈現(xiàn)大的帶光澤的黑色中心��,或呈現(xiàn)全部黑色的菌落;有些菌株為黃色菌落��,帶或不帶黑色中心。
XLD瓊脂里添加了木糖,腸道細菌幾乎都可以利用木糖��,只有志賀不利用��。所以志賀是無色的菌落。其中還添加了賴氨酸��,沙門氏菌也能利用木糖產(chǎn)酸,這樣就不能與其他腸道菌區(qū)分開��,但是大部分沙門會產(chǎn)賴氨酸脫羧酶��,在酸性條件下把賴氨酸脫羧后形成的尸胺是堿性��,會中和木糖產(chǎn)的酸,從而使菌落保持無色��。再配合硫化氫指示系統(tǒng),沙門就變成了我們看到的形態(tài)��。乳糖和蔗糖的存在可以讓產(chǎn)生賴氨酸脫羧酶的大腸菌群大量產(chǎn)酸,從而與沙門氏菌區(qū)分��。
四種常用培養(yǎng)基菌落形態(tài)分類如下
不同的廠家的沙門氏顯色培養(yǎng)基��,由于其培養(yǎng)基上的酶底物和顯色基團不同,所以形成的菌落特征就不同��,按照廠家的說明書判斷。
4. 初步生化
自選擇性瓊脂平板上分別挑取2個以上典型或可疑菌落,接種三糖鐵瓊脂,先在斜面劃線,再于底層穿刺;接種針不要滅菌,直接接種賴氨酸脫羧酶試驗培養(yǎng)基和營養(yǎng)瓊脂平板,于36℃士1 C培養(yǎng)18h~24h,必要時可延長至48h。
注意:三糖鐵瓊脂要配制為高層斜面,接種針挑取菌落��,于高層斜面上劃線��,再穿刺(穿刺針不要破壁��,不要穿透,距底部5mm左右即可)��;同時用穿刺過的接種針接種賴氨酸脫羧酶反應管(分為賴氨酸脫羧酶反應管和對照管��,兩者都有要接種��,表面覆蓋2-3滴液體石蠟��,防止氧化)��。
需要根據(jù)下表判定菌落的可疑性,來確定是否再進行下一步的生化鑒定��。
5. 生化鑒定
確定可疑菌后,需要進行生化鑒定��,若一個一個生化管去做��,過程十分的繁瑣��。根據(jù)國標“5.4.3”規(guī)定��,可疑采用生化鑒定試劑盒或全自動生化鑒定系統(tǒng)進行檢測��。
6. 血清學鑒定
血清學鑒定是十分必須的步驟��,可判定沙門氏菌是否被O多價抗原和H多價抗原血清凝集��。
采用的血清可以是進口的或者國內生產(chǎn)的��,但是國內血清的凝集性能有時不太好��,而進口血清又太貴��。所以僅是判定O多價和H多價凝集的��,用國產(chǎn)的就可以��。
(1)以無菌干凈的玻片為載體��,滴一滴生理鹽水��,接種管從營養(yǎng)瓊脂平面挑取少量菌體��,在生理鹽水中涂開��,緩緩涂��,觀察凝集情況��,排除自凝。
(2)滴一滴O多價血清于玻片上��,重復上述步驟��,判斷凝集情況��,一般情況都會凝集的。除非是有Vi抗原存在時(如鼠傷寒沙門氏菌)��,會阻止O血清凝集,可挑取菌體至1 mL生理鹽水中制成菌懸液��,于酒精燈煮沸在檢查��。
(3)滴一滴H多價血清于玻片上��,重復上述(1)中步驟��,判斷凝集情況��。若凝集效果不明顯��,需要用0.6%半固體瓊脂平板誘導��,帶菌落蔓延生長是,挑取邊緣部分進行檢查��。
典型凝集效果見下圖:
7. 關鍵控制點
a��、樣品處理
盡可能縮短解凍時間��,使竟爭菌群生長最少,并減小對沙門氏菌的損傷致病菌取樣一定要均勻并具有代表性(蛋黃蛋清混勻取樣)��。
b��、培養(yǎng)基及培養(yǎng)方面
(1)沒有一種培養(yǎng)基可疑準確無誤的篩選出沙門氏菌��,必須選擇多種選擇性培養(yǎng)基同時篩選,只能說顯色培養(yǎng)基綜合選擇性更強��。
(2)試劑和培養(yǎng)基的配置一定要嚴格按照說明書配置,是否需要高壓滅菌��,添加劑用量及培養(yǎng)基保存條件��。
(3)BS培養(yǎng)基是分離沙門氏菌的高效培養(yǎng)基��,特別適用于傷寒類的沙門氏菌��,不是所有的選擇性培養(yǎng)基都能有效分離出傷寒沙門氏菌和副傷寒沙門氏菌,BS是分離傷寒類沙門氏菌的首選培養(yǎng)基��。
(4)BS不能高壓��,不能過熱溶解��,只能在使用前一天配置,保存在陰暗處��,48h后失去選擇性,保存不當��,顏色變淺標明已經(jīng)開始減效。
(5)TTB的添加劑必須在棕色瓶儲存��,不能見光��,否則選擇性減弱��。TTB有碳酸鈣沉淀��,分裝時一定要搖勻��,碳酸鈣作用是消除和吸收有毒代謝產(chǎn)物��。TTB加入添加劑后就不能再加熱。
(6)SC種含有亞硒酸氫鈉��,劇毒物質��,使用時候要注意安全,當天使用當天配置��。
(7)TSI最好自己配置��,制備成高柱斜面��,有助于結果判讀
(8)從挑選可疑菌落開始��,建議每步都同時劃線營養(yǎng)瓊脂瓊脂��,確保每個菌落均為純菌。
c��、生化反應
(1)生化反應要用純菌落進行(從營養(yǎng)瓊脂中挑取單個菌落制備成適宜濃度的菌懸液)��。
(2)多種生化試驗同時測試可以提高檢測效率。